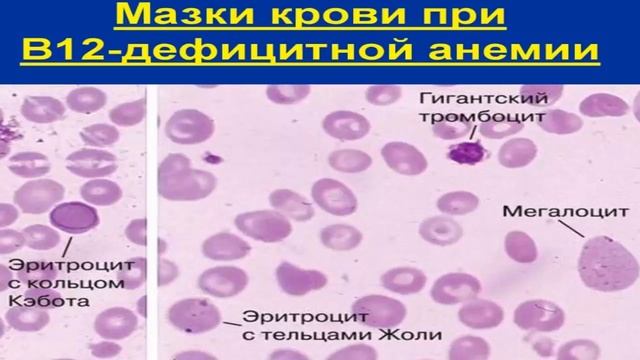
ЧТО ТАКОЕ АНИЗОЦИТОЗ В ОБЩЕМ АНАЛИЗЕ КРОВИ И ЧТО ЭТО ЗНАЧИТ

Сделай Сам на 100% - Новые видео
-
-
-
Вывоз старой мебели
Вывоз старой мебели из 3х комнатной квартиры в 5ти этажке. Ломаем, спускаем и укладываем в машине. Вывозим и утилизируем.
Смотреть -
Как нарисовать солнечные очки/Рисуем вместе/Часть 11
Всем привет! Вы попали на мой канал, и в этом видео я покажу вам как нарисовать солнечные очки. Обязательно пиши в комментариях новые идеи для видео, св...
Смотреть -
ЗАЧЕМ РОССИИ НОВАЯ АТОМНАЯ СТАНЦИЯ? || ⏱ Про Курскую АЭС
Короткий рассказ о том, зачем в Курской области строят новую атомную станцию. Информация об АЭС: http://rosenergoatom.ru/stations_projects/sayt-kurskoy...
Смотреть -
БЕЗ ЗАРЯДКИ НЕ ВКЛЮЧАЕТСЯ. Планшет PocketBook SURFpad 2 (скучный ремонт)
#невключается #ремонтпланшета #незаряжается Привет, дорогие мои!? Всех с наступившим Новым Годом!?Желаю всем всего наилучшего!?В данном видео рассмотрим...
Смотреть -
Лагерь в лесу своими руками - начало
Видео о том как я обустраивал место бивуака в лесу, делал каркас укрытия от дождя, стол и прочее. Турклуб Икра https://vk.com/club192036732 Другие в...
Смотреть -
-
Наборный ряд спицами с бахромой. Просто и понятно. An'Me
Привет, Я - Аня и это мой канал - вязание с An'Me/ В этом видео я рассказываю как набрать петли спицами с бахромой. МОИ ПОЛЕЗНЫЕ ССЫЛКИ: Instagram http...
Смотреть -
Scaring OLD PEOPLE With A Superbike - INDIA
Nothing to be taken offensive.... Always RESPECT elders... Thank You All For Watching! Drop A Like If You Enjoyed The Video! Else Drop a Dislike & Comme...
Смотреть -
ЧТО ТАКОЕ АНИЗОЦИТОЗ В ОБЩЕМ АНАЛИЗЕ КРОВИ И ЧТО ЭТО ЗНАЧИТ
Анизоцитоз -это такое состояние,при котором форма эритроцитов или лейкоцитов изменяется в размерах,что свидетельствует о присутствии протекания какого-т...
Смотреть -
Ведьмак 3. Геральт везет Цири к Эмгыру. Все варианты диалогов.
Как сделать Цири императрицей Нильфгаарда, и надо ли везти ее к Эмгыру? Брать или не брать деньги? Скрытые квесты в "Ведьмак 3" https://www.youtube.com/...
Смотреть -
В ПОГОНЕ ЗА ДЖЕКПОТОМ. 300000 Серебра || Мобильная Аватария
В этом видео я потрачу золото на фишки в мобильной аватарии и прокручу колесо удачи 160 раз. Что можно выиграть? Сколько можно заработать? Смотрите это ...
Смотреть -
Как достичь невозможного в Трейдинге. Жёсткий логический подход. Сергей Змеев. 18+
http://neuro-insider.ru/ - Здесь познают себя и зарабатывают миллионы на фондовом рынке! Чем хороша торговля на рынке - там нет сезонных рисков, сове...
Смотреть -
Сколько денег нужно студенту в 2021 году?
?Приятного просмотра ? Спасибо большое Тебе, что подписался(-ась) и поставил(-ла) лайк??❤️ Чуть больше меня в инстаграме: https://www.instagram.com/yul...
Смотреть -
ДРУГ ТЫ МНЕ ИЛИ НЕ ДРУГ ? ВРАГ ТЫ МНЕ ИЛИ НЕ ВРАГ ? Гадание таро.
1 вариант 00:00 2вариант 06:40 3 вариант 11:14 4 вариант 14:30 Для личниго расклпда пишите на номер телефона +7(916)-018-66-68 WhatsApp ( режим пер...
Смотреть -
#Гуляем_со_щенком #как_приучить_щенка_к_выгулу
#французкийбульдог# #щенок_на_улице# #карантинпозади ВОТ ТАКИЕ МЫ ГУЛЯЕМ, ПРОГУЛКА ПЕРВАЯ МОЯ❤️??
Смотреть -
Размеры , длины тяг , дистанционного запуска ПД 10 на Тракторе МТЗ 82\80.
Возможно кто то за хочет сделать дистанционный запуск из кабины на МТЗ с ПД 10. В данном видео я покажу , расскажу объясню принцип и размеры тяг . Я В...
Смотреть -
PHP CRUD (Create, Read, Update, Delete) Tutorial With MySQL + Bootstrap 4 # PART 1
Initial code - https://github.com/pknowledge/php_crud_base Welcome to the first video on PHP CRUD (Create, Read, Update, Delete) Tutorial with MySQL + ...
Смотреть -
Как почистить банан #22
Подписывайся на канал - http://www.youtube.com/user/howtomodny Подписывайся на наш паблик - http://vk.com/public11230487
Смотреть